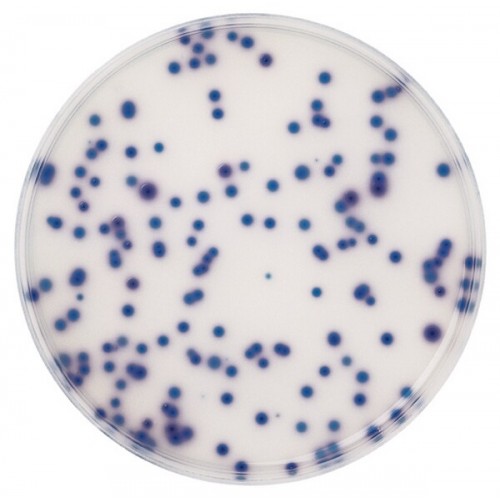

CHROMOCULT COLIFORM AGAR CROMOGÊNICO MERCK - 500g
Modelo: 1104260500
-
R$5.071,72
ou até 3x de R$1.690,57 sem juros
Economize 5% no PIX: R$4.818,13
ou 3.5% no boleto: R$4.894,21
Consulte aqui o valor do frete e prazo de entrega
Descrição
CHROMOCULT COLIFORM AGAR GRANULADO CROMOGÊNICO MERCK
RENDIMENTO 26,5g/l APROVADO PELA AOAC CERTIFICADO Nº 020902
EMBALAGEM 500GR
Chromocult® Coliformes Agar
Agar seletivo para a detecção simultânea de coliformes totais e E. coli em amostras de água potável e alimentos processados.
Finalidade
Chromocult® Coliformes Agar é um meio de cultura cromogênico seletivo e diferencial projetado para uso em laboratórios de microbiologia analisando comida e água. Dentro de 24 horas, este meio permite a detecção , diferenciação e contagem de E. coli e coliformes de água potável e matrizes de alimentos processados, como salsichas , frango cozido e leite desnatado seco.
O processo de fabricação de alimentos e água , muitas vezes resultar em lesão metabólica para os microorganismos e / ou redução dos membros microbianas. lesão microbiana sub letal é causada por tratamento térmico ou químico , bem como armazenamento em condições congelados, secos ou refrigerados.
Meios de cultura tradicionais utilizados para a detecção de coliformes / E. coli , muitas vezes contêm sais biliares ou biliares de boi para inibir as bactérias gram -positivas . Estes fortes inibidores , no entanto pode limitar o crescimento dos microrganismos selectivos se eles já estão sub letalmente danificados.
A seleção cuidadosa de inibidores usados no meio seletivo é necessária para garantir o crescimento e recuperação destes microorganismos danificados.
Chromocult® Coliformes Agar contém Tergitol® 7, como um inibidor de bactérias Gram - positivas, que não tem nenhum efeito negativo sobre o crescimento do coliformes / E. coli alvo. Chromocult® Coliformes Agar é, portanto, o meio ideal para a detecção de coliformes / E. coli na água potável e em alimentos processados.
Composição típica (g / litro)
Peptona 3,0;
cloreto de sódio 5,0;
di-hidrogenofosfato de sódio 2,2;
fosfato de hidrogénio di-sódio 2,7;
piruvato de sódio 1,0;
triptofano 1,0;
ágar-ágar 10,0;
sorbitol 1,0;
tergitol ® 7 0,15;
6-cloro-3-indoxil-beta-Dgalactopyranoside 0,2;
5-bromo-4-cloro-3-indoxil-beta-D-glucorónico ácido 0,1;
isopropil-beta-Dthiogalactopyranoside 0,1.
Preparação
Preparação do meio agar
Suspender 26,5 g em 1000 ml de água purificada e aquecer (até 95°C) com agitação frequente até que esteja completamente dissolvido (aprox. 35 min).
Não autoclave! Não sobreaquecer!
Imediatamente resfrie o meio no banho de água a 45-50° C.
pH: 6,8 ± 0,2 a 25° C.
Resultados
Conte as colônias azul escuro a violeta como E. coli e as colônias vermelho salmão como outros coliformes.
O total de todas as colônias vermelho e azul é a contagem de coliformes totais.
Alguns E. coli (3-4%) são-ß-glucuronidase negativos e aparecem como colônias de salmão-vermelho, por exemplo, Cepas de E. coli O157. Flora acompanhante aparece como colônias incolores, com exceção de alguns organismos, que possuem atividade ß-D-glucuronidase. Estas colônias aparecem na cor azul claro a turquesa.
A contagem de coliformes totais não deve exceder 150 CFU típicas e 300 CFU totais (coliformes totais e bactérias que acompanham) por placa e 100 CFU típica e 200 CFU total por filtro de membrana, respectivamente. Acima destes níveis, as colônias não podem ser contados com precisão. As amostras, que se espera que venham a exceder estes limites máximos, deve ser diluído antes da inoculação.
Calcular o número de E. coli e outros coliformes por mililitro ou por grama de amostra a partir do número de colónias característivas nas placas.
Mais informações solicitar a equipe Pró-Análsie ou consultar o site www.merckmillipore.com.
RENDIMENTO 26,5g/l APROVADO PELA AOAC CERTIFICADO Nº 020902
EMBALAGEM 500GR
Chromocult® Coliformes Agar
Agar seletivo para a detecção simultânea de coliformes totais e E. coli em amostras de água potável e alimentos processados.
Finalidade
Chromocult® Coliformes Agar é um meio de cultura cromogênico seletivo e diferencial projetado para uso em laboratórios de microbiologia analisando comida e água. Dentro de 24 horas, este meio permite a detecção , diferenciação e contagem de E. coli e coliformes de água potável e matrizes de alimentos processados, como salsichas , frango cozido e leite desnatado seco.
O processo de fabricação de alimentos e água , muitas vezes resultar em lesão metabólica para os microorganismos e / ou redução dos membros microbianas. lesão microbiana sub letal é causada por tratamento térmico ou químico , bem como armazenamento em condições congelados, secos ou refrigerados.
Meios de cultura tradicionais utilizados para a detecção de coliformes / E. coli , muitas vezes contêm sais biliares ou biliares de boi para inibir as bactérias gram -positivas . Estes fortes inibidores , no entanto pode limitar o crescimento dos microrganismos selectivos se eles já estão sub letalmente danificados.
A seleção cuidadosa de inibidores usados no meio seletivo é necessária para garantir o crescimento e recuperação destes microorganismos danificados.
Chromocult® Coliformes Agar contém Tergitol® 7, como um inibidor de bactérias Gram - positivas, que não tem nenhum efeito negativo sobre o crescimento do coliformes / E. coli alvo. Chromocult® Coliformes Agar é, portanto, o meio ideal para a detecção de coliformes / E. coli na água potável e em alimentos processados.
Composição típica (g / litro)
Peptona 3,0;
cloreto de sódio 5,0;
di-hidrogenofosfato de sódio 2,2;
fosfato de hidrogénio di-sódio 2,7;
piruvato de sódio 1,0;
triptofano 1,0;
ágar-ágar 10,0;
sorbitol 1,0;
tergitol ® 7 0,15;
6-cloro-3-indoxil-beta-Dgalactopyranoside 0,2;
5-bromo-4-cloro-3-indoxil-beta-D-glucorónico ácido 0,1;
isopropil-beta-Dthiogalactopyranoside 0,1.
Preparação
Preparação do meio agar
Suspender 26,5 g em 1000 ml de água purificada e aquecer (até 95°C) com agitação frequente até que esteja completamente dissolvido (aprox. 35 min).
Não autoclave! Não sobreaquecer!
Imediatamente resfrie o meio no banho de água a 45-50° C.
pH: 6,8 ± 0,2 a 25° C.
Resultados
Conte as colônias azul escuro a violeta como E. coli e as colônias vermelho salmão como outros coliformes.
O total de todas as colônias vermelho e azul é a contagem de coliformes totais.
Alguns E. coli (3-4%) são-ß-glucuronidase negativos e aparecem como colônias de salmão-vermelho, por exemplo, Cepas de E. coli O157. Flora acompanhante aparece como colônias incolores, com exceção de alguns organismos, que possuem atividade ß-D-glucuronidase. Estas colônias aparecem na cor azul claro a turquesa.
A contagem de coliformes totais não deve exceder 150 CFU típicas e 300 CFU totais (coliformes totais e bactérias que acompanham) por placa e 100 CFU típica e 200 CFU total por filtro de membrana, respectivamente. Acima destes níveis, as colônias não podem ser contados com precisão. As amostras, que se espera que venham a exceder estes limites máximos, deve ser diluído antes da inoculação.
Calcular o número de E. coli e outros coliformes por mililitro ou por grama de amostra a partir do número de colónias característivas nas placas.
Mais informações solicitar a equipe Pró-Análsie ou consultar o site www.merckmillipore.com.
Etiquetas: agar coliforme cromogênico, chromocult